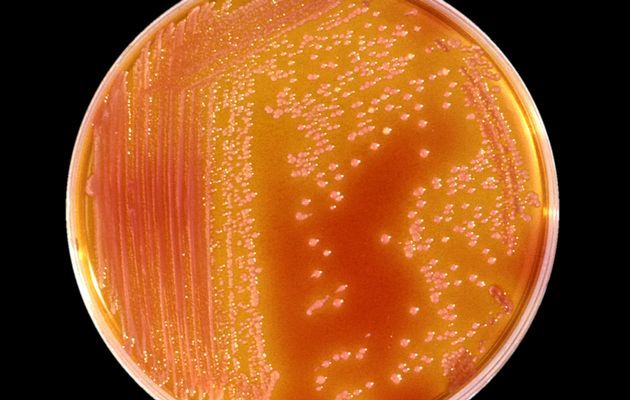

Γήινα μικρόβια βρέθηκαν να επιβιώνουν στις συνθήκες του Άρη
Ανθεκτικά μικρόβια που επιβιώνουν σε μια ποικιλία από περιβάλλοντα στη Γη επέζησαν όταν τοποθετήθηκαν σε έναν θάλαμο που προσομοιώνει τη χαμηλή πίεση και θερμοκρασία στην επιφάνεια του Άρη -μια εντυπωσιακή ανακάλυψη που ίσως επηρεάσει τις έρευνες για εξωγήινη ζωή.
Spotlight
-

Έως τη Μεγάλη Τετάρτη το δώρο του Πάσχα - Πώς το υπολογίζετε
-

Όλα στη φορά! - Οι νέες αλλαγές στην εφαρμογή του Messenger ίσως ενοχλήσουν κάποιους
-

Βόλτα Μητσοτάκη στον Άγιο Δημήτριο – Έθεσε πάλι διλήμματα και ζήτησε συσπείρωση
-

Ο εβραιοαμερικανός κοσμήτορας του Μπέρκλεϋ που έδιωξε από το σπίτι του Παλαιστίνιους φοιτητές
Ανθεκτικά μικρόβια που επιβιώνουν σε μια ποικιλία από περιβάλλοντα στη Γη επέζησαν όταν τοποθετήθηκαν σε έναν θάλαμο που προσομοιώνει τη χαμηλή πίεση και θερμοκρασία στην επιφάνεια του Άρη -μια εντυπωσιακή ανακάλυψη που ίσως επηρεάσει τις έρευνες για εξωγήινη ζωή.
Το πρώτο μικρόβιο που βρέθηκε να αντέχει αυτές τις συνθήκες ήταν ένα βακτήριο με την ονομασία Serratia liquefaciens, το οποίο απαντάται στο ανθρώπινο δέρμα, τις τρίχες και τους πνεύμονες, καθώς και σε ψάρια και φυτά.
Οι ερευνητές διαπίστωσαν ότι το βακτήριο αντέχει στο ακραίο κρύο, τις υψηλές συγκεντρώσεις διοξειδίου του άνθρακα, καθώς και στη χαμηλή πίεση της αρειανής ατμόσφαιρας, η οποία δεν ξεπερνά τα 7 millibar. Στη Γη, η ατμοσφαιρική πίεση στο επίπεδο της θάλασσας είναι 1.000 millibar.
«Ήταν μεγάλη έκπληξη» σχολιάζει στο Reuters ο Άντριου Σούργκερ, μικροβιολόγος του Πανεπιστημίου της Φλόριντα.
Το πείραμα, πάντως, το οποίο πραγματοποιήθηκε σε εργαστήριο δίπλα στο Διαστημικό Κέντρο Κένεντι στη Φλόριντα, δεν εξέτασε την αντίδραση των μικροβίων στη σκληρή υπεριώδη ακτινοβολία που είναι γνωστό ότι λούζει την επιφάνεια του γειτονικού πλανήτη.
Είκοσι πέντε άλλα είδη μικροβίων που υποβλήθηκαν στη δοκιμασία τελικά δεν επιβίωσαν, αναφέρει η ομάδα του Δρ Σούργκερ. Σε επόμενη φάση, οι ερευνητές εξέτασαν ακόμα 10.000 είδη μικροβίων που είχαν βρεθεί σε βάθος μερικών δεκάδων μέτρων μέσα στο μονίμως παγωμένο έδαφος της Σιβηρίας.
Έξι από τα είδη αυτά, όλα τους μέλη του γένους Carnobacterium όχι μόνο επιβίωσαν στο θάλαμο αλλά μπόρεσαν και να αναπτυχθούν.
Τα αποτελέσματα του πειράματος δείχνουν να αφήνουν ανοιχτό το ενδεχόμενο να μολυνθεί το περιβάλλον του Άρη από μικρόβια που καταφθάνουν εκεί με τις γήινες αποστολές. Η NASA καταβάλλει κάθε προσπάθεια να αποστειρώνει τα σκάφη πριν από την εκτόξευσή τους, ωστόσο το ενδεχόμενο μόλυνσης δεν μπορεί ποτέ να αποκλειστεί.
Το Serratia liquefaciens χρησιμοποιήθηκε στη μελέτη επειδή «το είδος αυτό έχει ανακτηθεί από διαστημικά σκάφη» σχολιάζει ο Σούργκερ.
Επιπλέον, όμως, τα αποτελέσματα δίνουν μια εικόνα για τις μορφές μικροβίων που θα μπορούσαν ενδεχομένως να έζησαν ή να ζουν στον Άρη.
Το κατά πόσο ο Κόκκινος Πλανήτης ήταν ποτέ φιλόξενος για τη ζωή είναι ένα ερώτημα που καλείται τώρα να απαντήσει το ρομπότ Curiosity της NASA, το οποίο μελετά από τον περασμένο Αύγουστο τον αρχαίο Κρατήρα Γκέιλ.
Πίσω στη Γη, επόμενο βήμα του Δρ Σούεγκερ είναι να υποβάλλει τα μικρόβια σε ακόμα πιο αντίξοες συνθήκες, όπως υψηλές συγκεντρώσεις αλάτων, ισχυρή υπεριώδη ακτινοβολία και λιγότερο νερό.
Θα προσπαθήσει επίσης να μελετήσει το γενετικό προφίλ και τις μεταβολικές ιδιαιτερότητες του Serratia liquefaciens.
Οι μελέτες του ερευνητή δημοσιεύτηκαν το Δεκέμβριο στην αμερικανική επιθεώρηση PNAS και αυτή την εβδομάδα στην επιθεώρηση Astrobiology.
Newsroom ΑΛΤΕΡ ΕΓΚΟ
Ακολουθήστε το in.gr στο Google News και μάθετε πρώτοι όλες τις ειδήσεις

![Bitcoin: Εγένετο halving- Πού θα εστιάσουν οι επενδυτές [γραφήματα]](https://www.ot.gr/wp-content/uploads/2024/03/ot_bitcoin222-300x300.png)










































 Αριθμός Πιστοποίησης Μ.Η.Τ.232442
Αριθμός Πιστοποίησης Μ.Η.Τ.232442